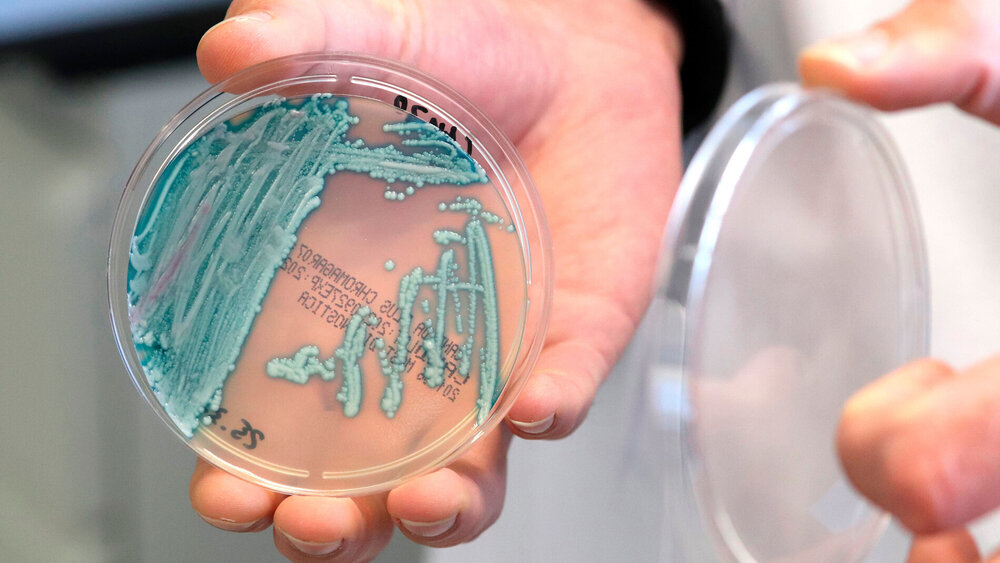

Pilzinfektionen mit Candida auris nehmen stark zu
Für gesunde Menschen ist eine Besiedlung mit dem Pilz Candida auris in der Regel ungefährlich, die meisten merken nicht einmal etwas davon. Bei anderen Gruppen – beispielsweise Menschen mit einem geschwächten Immunsystem oder Patienten auf Intensivstationen – ist die Gefahr größer. Gelangt Candida auris in ihren Blutkreislauf, droht eine Sepsis, die in gut der Hälfte aller Fälle tödlich endet. Vor allem für Krankenhäuser, Pflegeeinrichtungen und Seniorenheime stellt der Pilz deshalb eine Bedrohung dar.
Nach Einschätzung von Dr. Christian Bellmann, Senior Medical Advisor bei der Pfizer Pharma GmbH, führt vor allem der Klimawandel zu einem Anstieg an Infektionen bereits bekannter und neuer Erreger. Gegenüber der Plattform Land der Gesundheit sagte er, der Klimawandel habe direkte Konsequenzen auf Temperaturanstieg, Feuchtigkeitshaushalt sowie heftige Windereignisse und verändere dadurch die Rahmenbedingungen für wichtige Zwischenwirte wie Mücken oder Zecken. Darüber hinaus komme es auch zu einem Anstieg der Virulenz, der Ausbreitung und somit der Übertragbarkeit von Umweltpathogenen.
An die Erhöhung der Umgebungstemperaturen durch den Klimawandel haben sich einige Pilze bereits gewöhnt, wodurch zum Beispiel Candida auris – ursprünglich ein Pflanzensaprophyt – die Thermotoleranz entwickelte, die es ihm ermöglichte, auf Vögeln weit verbreitet zu werden. „Der Übergang auf den Menschen und der Eintrag in das Krankenhausumfeld war dann der kleinere Schritt“, so Bellmann. „Im Krankenhaus traf der Pilz auf immungeschwächte Wirte, deren Besiedlung die Ausbreitung noch verstärkte.“ Das Problem laut Bellmann: Schätzungsweise 60 Prozent der Patienten, die sich mit Candida auris infizieren, sterben an der Infektion.
Candida auris
Seit der erstmaligen Beschreibung des Hefepilzes Candida auris in Japan im Jahr 2009 wird global ein kontinuierlicher Anstieg der Fallzahlen beobachtet. Mittlerweile ist der Pilz weltweit verbreitet und in einigen Regionen wie Indien und Südafrika und regional auch in Spanien und Italien endemisch. Anders als bei anderen Candida-Arten kommt es bei dieser Hefepilzart insbesondere in Gesundheits- und Pflegeeinrichtungen regelmäßig über direkten und indirekten Kontakt zu schwer eindämmbaren Ausbruchsgeschehen. Die Behandlung von Candida auris-Infektionen wird durch das Potenzial des Erregers, Resistenzen gegen alle verfügbaren Antimykotika-Klassen zu entwickeln, erheblich erschwert. Diese Eigenschaften führten unter anderem zum Einschluss des Pilzes in die höchste Priorisierungskategorie des amerikanischen Centers for Disease Prevention and Control (CDC) und der Weltgesundheitsorganisation (WHO). In Deutschland unterliegen seit Juli 2023 sowohl der Nachweis von Candida auris aus Blut und primär sterilen Materialien als auch Ausbruchsgeschehen des Erregers der Meldepflicht gemäß Paragraf 6 und 7 des Infektionsschutzgesetzes.
Wissenschaftler des Nationalen Referenzzentrums für Invasive Pilzinfektionen (NRZMyk) haben jetzt einen deutlichen Anstieg der Candida auris-Fallzahlen in Deutschland registriert. Wurden in den Vorjahren jeweils zwölf Fälle an das Referenzzentrum gemeldet, waren es im vergangenen Jahr 77. Diese Zahlen hat das Forschungsteam jetzt im Epidemiologischen Bulletin des Robert Koch-Instituts (RKI) veröffentlicht. In ihrer Studie werfen die Autoren nicht nur einen Blick auf die Gesamtzahlen. Sie gehen auch detailliert auf deren Entwicklung und die einzelnen Übertragungsereignisse ein. Dabei unterscheiden sie zwischen einer reinen Kolonisation und einer invasiven Infektion.
In den USA hat sich die Fallzahl in zehn Jahren verhundertfacht
Demnach lag in 58 der 77 beschriebenen Fälle eine Kolonisation der Patienten vor, in 13 Fällen kam es zu einer Infektion. In sechs Fällen blieb der Status unklar. Von den Patienten mit initialer Kolonisation oder unklarem Infektionsstatus entwickelten im Verlauf fünf eine invasive Infektion. Neben einem relevanten Anstieg einzelner Infektionen ohne nachgewiesene direkte Ansteckungen weiterer Personen konnten auch vier unabhängige Ausbruchsgeschehen aufgedeckt werden. Die Mehrheit der nachgewiesenen Fälle konnte nachträglich einem spezifischen Ausbruch zugeordnet werden. Aufgrund der aktuellen Meldepflicht fehlte bei diesen Fällen zunächst die infektiologische Relevanz, so dass der Ausbruch zunächst unentdeckt blieb und die Übertragungsereignisse letztlich nicht frühzeitig unterbunden werden konnten.
In den USA beobachtet die Gesundheitsbehörde CDC schon seit Jahren, wie sich die gemeldeten Candida auris-Fälle vervielfachen. Laut offiziellen Angaben gab es:
2013 bis 2016: 77 Fälle
2017: 445 Fälle
2018: 1.027 Fälle
2019: 1.555 Fälle
2020: 2.067 Fälle
2021: 5.514 Fälle
2022: 8.131 Fälle
Die Zahlen für Deutschland kommentiert Dr. Alexander M. Aldejohann vom NRZMyk trotzdem so: „Der enorme Anstieg 2023 hat uns überrascht. Ausschlaggebend sind hier vor allem auch Ausbruchsgeschehen in Krankenhäusern. Wenn diese nicht frühzeitig erkannt und adäquat bekämpft werden, sind sie später sehr schwer in den Griff zu bekommen.“ Zu diskutieren wäre nach Ansicht der Beteiligten die erst 2023 eingeführte gesetzliche Meldepflicht. Diese erfasse nur einen kleinen Teil der Fälle. Ursache dafür sei in erster Linie ein hoher Anteil klinisch nicht relevanter Nachweise, die gemäß des aktuellen Infektionsschutzgesetzes keiner Meldepflicht unterliegen. Gegenwärtig müssen Kolonisationen nur dann gemeldet werden, wenn sie eine Folge von Übertragung in Krankenhäusern und ähnlichen Einrichtungen sind.
„Eine allgemeine Meldepflicht für jeden Labornachweis könnte helfen“
Die Autoren regen deshalb an, über eine generelle Meldepflicht für alle Candida auris-Fälle nachzudenken. Mit frühzeitig und konsequent durchgeführten Screening- und Hygienemaßnahmen bei allen Nachweisen, unabhängig von deren klinischer Relevanz, könnte ihrer Meinung nach einer weiteren Ausbreitung von Candida auris wirkungsvoll entgegengetreten werden. „Wir müssen davon ausgehen, dass die Candida auris-Fälle in Deutschland – so wie in anderen Ländern auch – weiter zunehmen“, befürchten sie. Weil Infektionen durch diesen Pilz oft schwer zu behandeln sind, gelte: „Je länger wir das verzögern können, umso besser. Eine allgemeine gesetzliche Meldepflicht für jeden Labornachweis von Candida auris könnte hier helfen – und zwar insbesondere in der jetzigen Phase, wo die Fallzahlen noch sehr niedrig sind.“
Aldejohann, Alexander M. et al., Zunahme von Candida auris in Deutschland im Jahr 2023., Epidemiologisches Bulletin 2024; 02. Mai 2024; DOI: 10.25646/12004